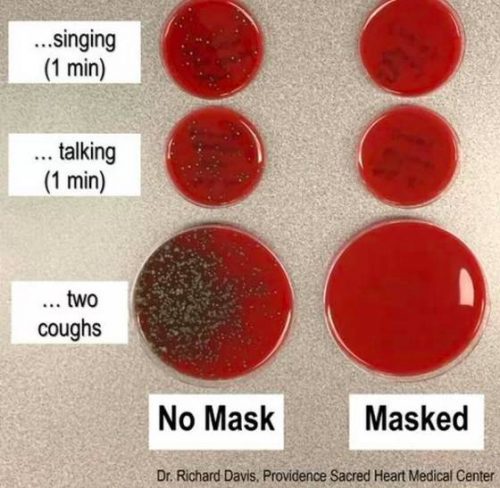

Маске удается блокировать мельчайшие частицы влаги, вылетающие из носа и рта, что можно видеть на снимках, которые исследователь разместил в соцсети.
Директор лаборатории клинической микробиологии в Providence Sacred Heart (США) Ричард Дэвис решил, наконец, наглядно показать роль медицинской маски в защите организма от вирусов. Просто ученый устал отвечать многочисленным знакомым и своим подписчикам на один и тот же вопрос, защищает ли маска от коронавируса. А заодно и продемонстрировал, как легко и быстро распространяется коронавирус, если пренебрегать мерами предосторожности, сообщает «ЕГ».
«Что делает маска? Блокирует мельчайшие капли, вылетающие из вашего рта и горла», - написал ученый в Twitter, описав два эксперимента.
Первый эксперимент: Ричард Дэвис чихал, разговаривал, пел, кашлял. Причем все эти действия он совершал над чашкой с агаровой культурой. При этом сначала он был в маске, потом снял ее для чистоты эксперимента. Результаты показали, что ношение маски сдержало попадание почти всех капель в чашку с агаром. А вот в случае, когда маски на лице не было, в чашке появилась бактериальная колония.
Второй эксперимент понадобился доктору, чтобы выяснить, как далеко разлетаются капли. Вирусолог поставил открытые чашки на расстоянии 0,600, 1,200 и 1, 800 метров и сильно кашлял в течение нескольких секунд. И опять – в маске и без. На фото видны результаты. Исследователь уточнил, что хоть в экспериментах и участвовали бактерии, а не вирусные частницы, но ему было важно показать сам воздушно-капельный путь передачи инфекции.
Наглядный эксперимент американского ученого оказался своевременным и актуальным, поскольку споры о том, стоит носить медицинские маски и защищают ли они от коронавируса, идут до сих пор. Некоторые утверждают, что здоровым людям этого делать не стоит. В частности, Всемирная организация здравоохранения вообще сначала посчитала ношение масок вредным для здоровых людей. Затем стала убеждать, что ношение маски обязательно для всех, особенно в общественном месте.